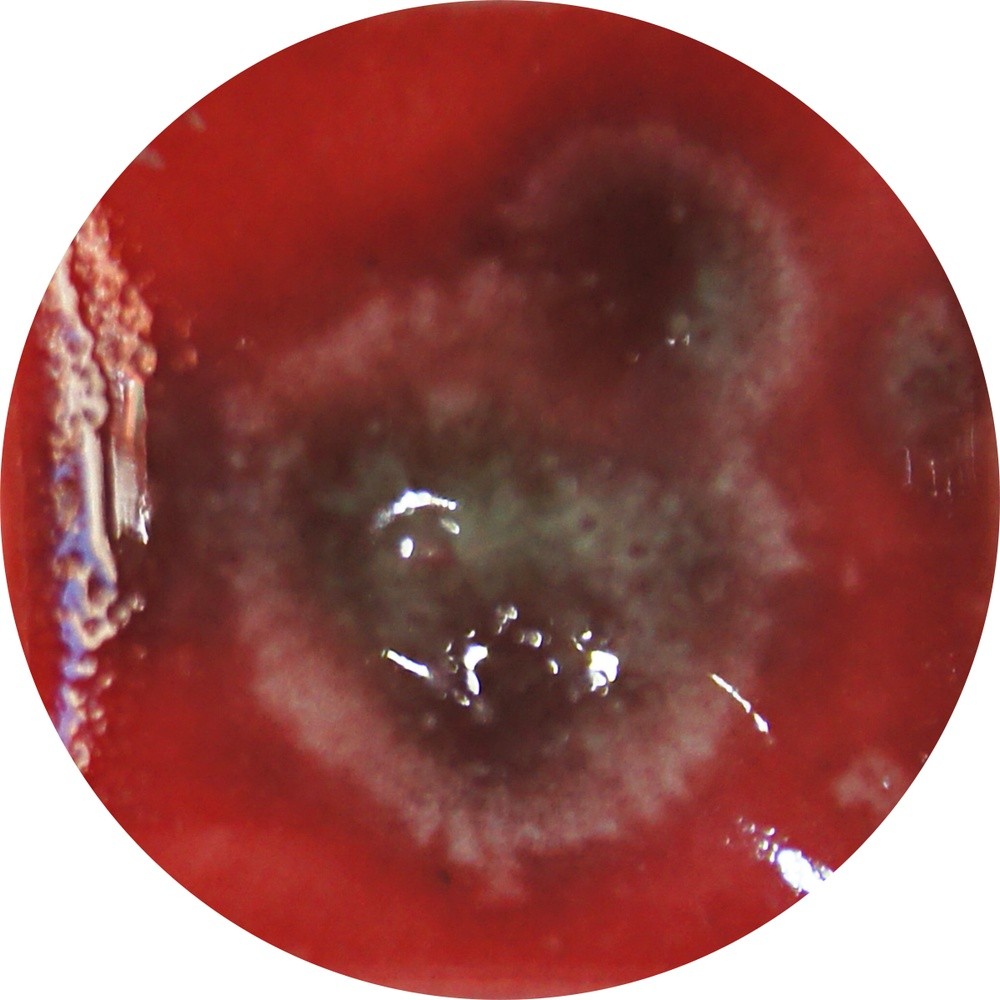
FG084H chrysanthos Lady Bird Fantasy Glaze H

WE SHIP ALL OVER CYPRUS, GREECE AND ABROAD
EN
ΕΛ WE SHIP ALL OVER CYPRUS, GREECE AND ABROAD
EN
ΕΛ WE SHIP ALL OVER CYPRUS, GREECE AND ABROAD
EN
ΕΛ





AMACO SEMI MOIST UNDERGLAZES SMUGS
AMACO DIPPING AND LAYERING (DL)
AMACO HIGH FIRE (HF)
AMACO KILN ICE (KI)
CHRYSANTHOS 3D THIN TRAILING GLAZE H
Out of Stock
 3DT01H CHRYSANTHOS 3D THIN TRAIL GLAZE H WHITE€5.20
3DT01H CHRYSANTHOS 3D THIN TRAIL GLAZE H WHITE€5.20